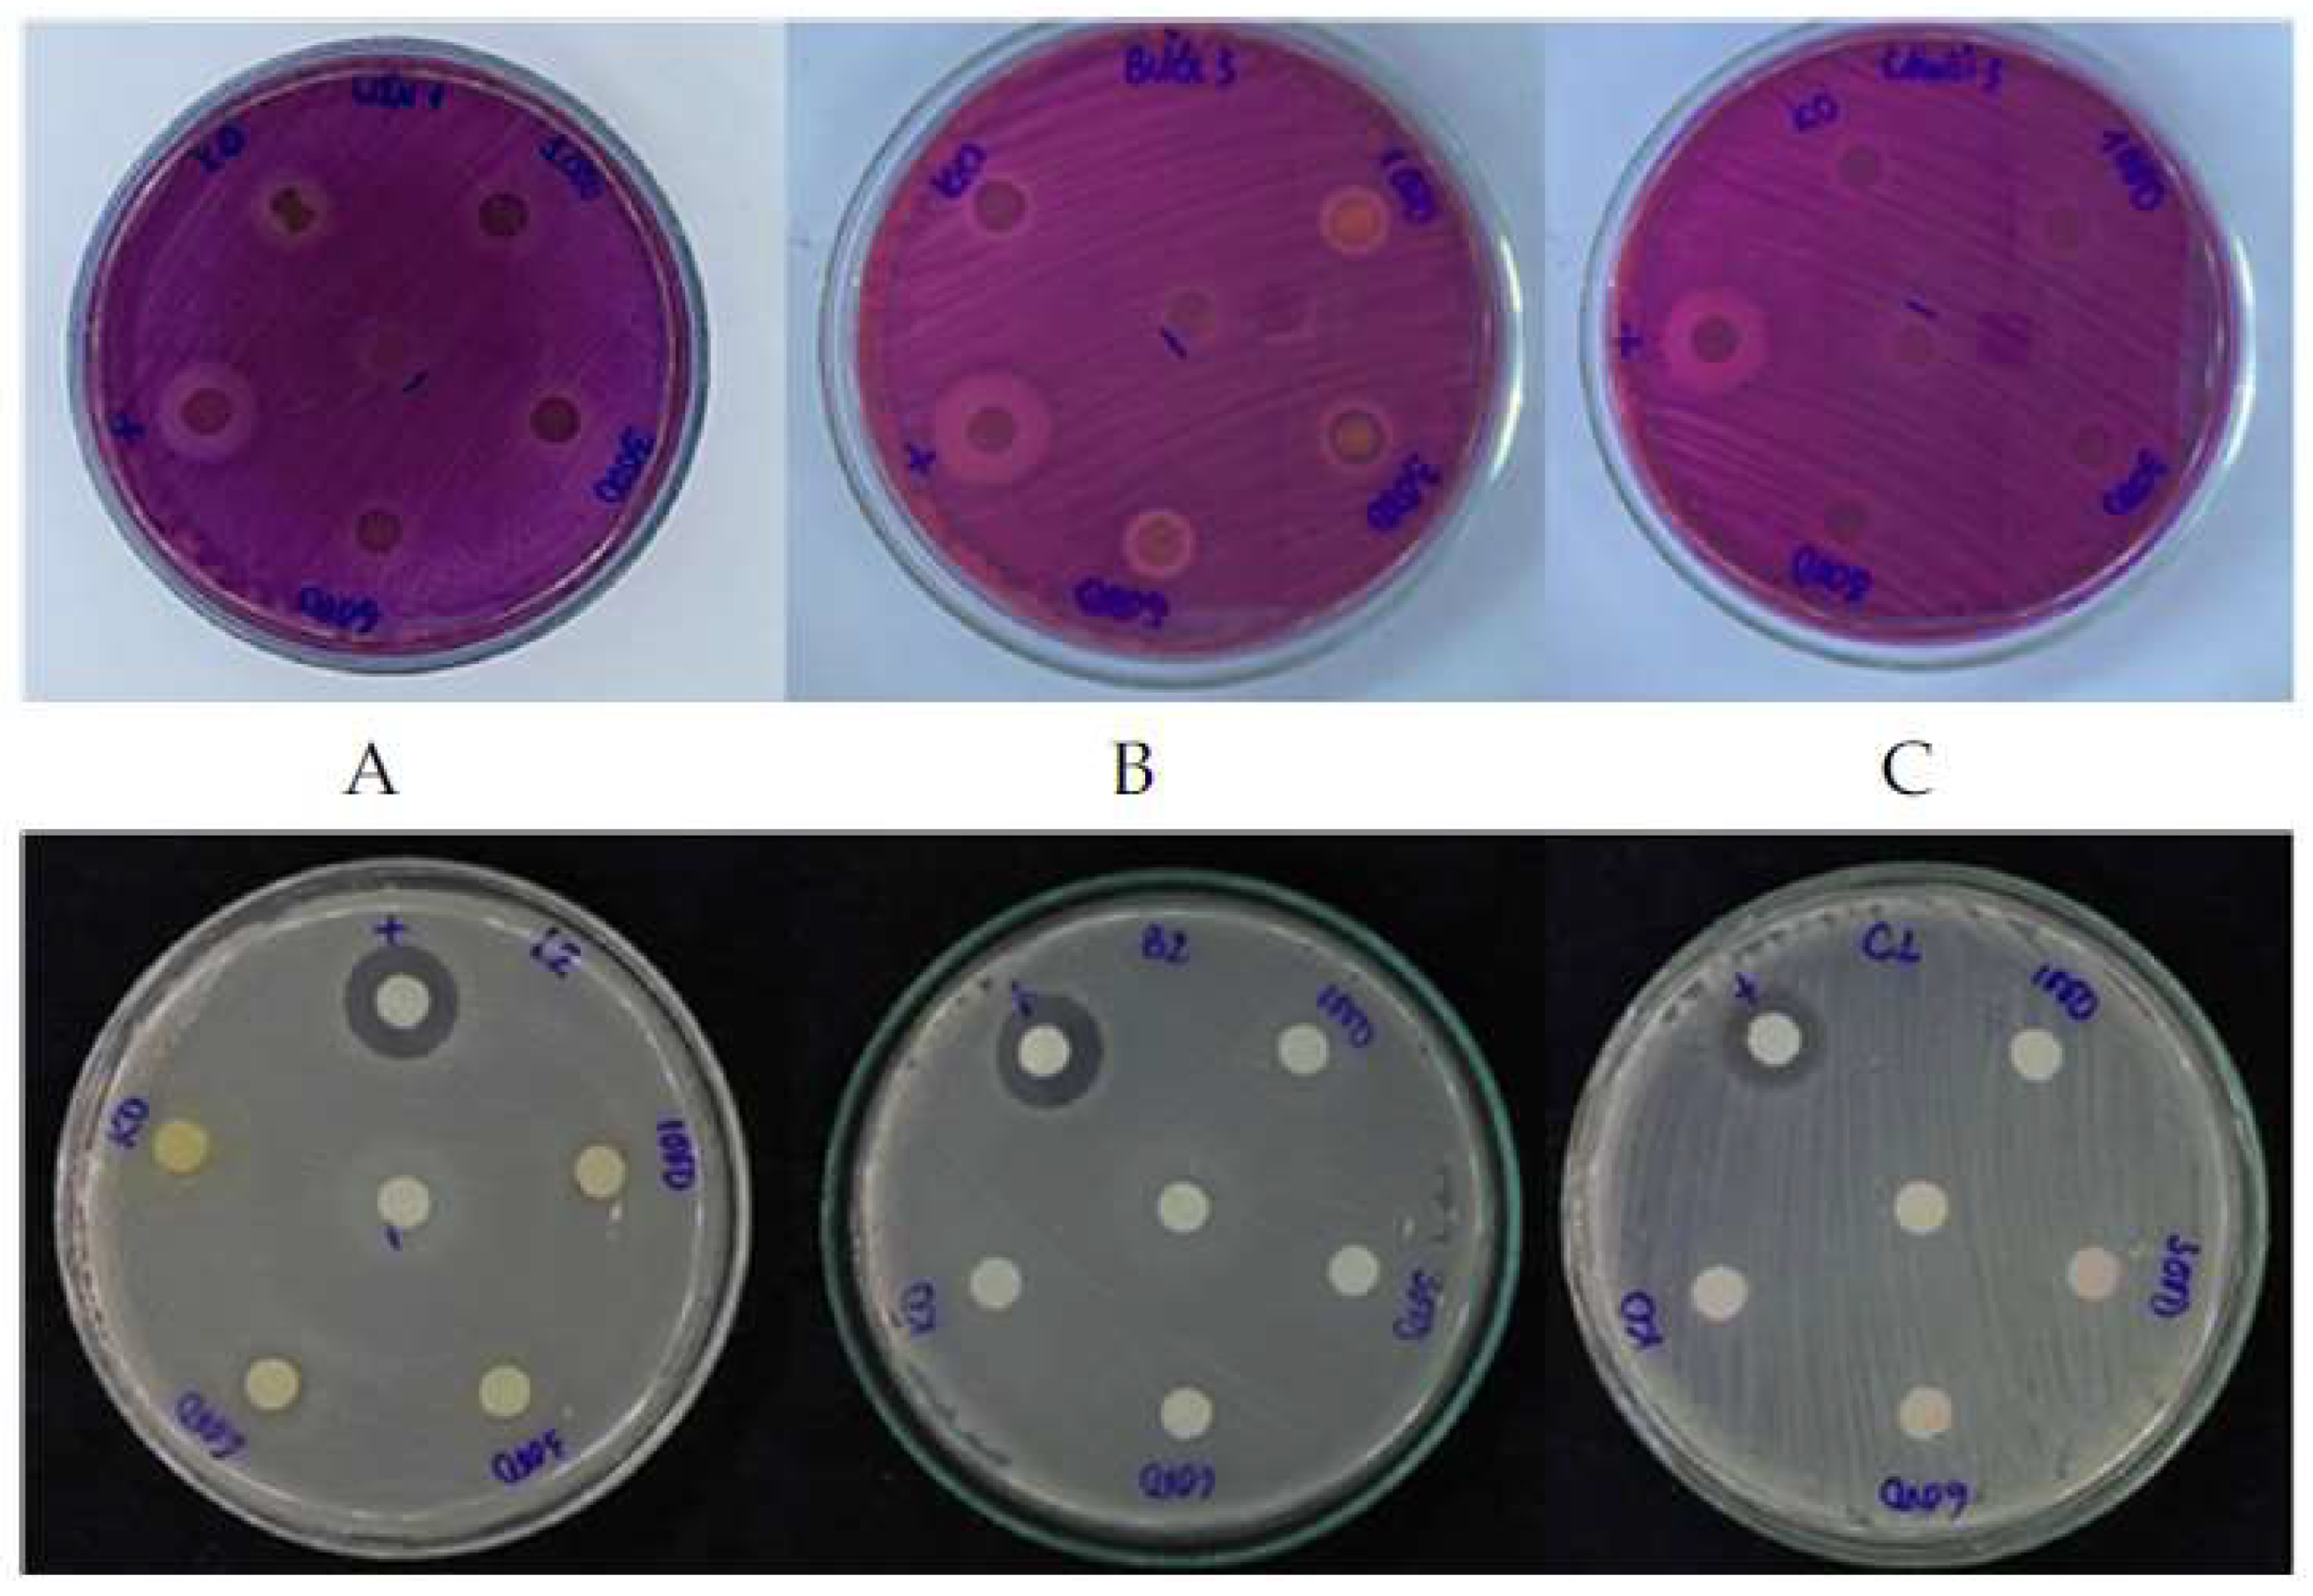
Cosmetics 08 00033 g001

1. Introduction
People all around the world consume a huge amount of fruit every year. Much research has demonstrated the importance of fruit peels in a variety of aspects, such as fertilizer, biofuel, enzymes, food, or cosmetics. There were about 102 million tons of banana consumed in 2018, and the peel represents the 35% of the weight. Traditionally, banana peel waste has been used as a medicinal source for the treatment of anemia, diabetes, inflammation, and cancer, due to its high amount of phenolic and fiber [
1]. Moreover, pomelo peel contains many bioactive compounds, such as coumarins and flavonoids, polyphenols, and vitamins, that impact health benefits beyond basic nutrition [
2]. According to Zhai et al. [
3], pomegranate is a popular fruit with a variety of products, such as juice, wine, and jam, in which its peel contains a large amount of phenolics, flavonoids, and tannins, which are commonly used in medicine.
Pectin is a heteropolysaccharide that contributes to the plant cell structure and has been applied in food and pharmaceuticals. It is mainly composed of α-1-4 d-galacturonic acid and some neutral sugars, which have been demonstrated to be safe in cosmetics [
4]. However, there has been a limited application of these substances in cosmetic discipline. The extraction of fermented fruit peel is targeted to promote economic value, maximize the application of agricultural products, and minimize waste into the environment. The study aims to compare the antioxidant, antibacterial, and anti-UVB abilities of three fermented fruit peel extracts, including pomegranate, pomelo, and banana peel by pectinase enzyme.
4. Discussion
This research focused on the preliminary biological activities of fermented fruit peels. Some compounds present in fruit peels, such as pectin, polyphenols, flavonoids, and terpenes, play an important role in fruit peel bioactivities. Ruangtong et al. [
10] has synthesized a nano material by ZnO and banana peel extract applied in cancer treatment, thanks to the available bio-compounds. Pomegranate peels have been demonstrated as a valuable source of antioxidant compounds, with a high amount of ellagic acid and flavonoids [
11]. In addition, pomelo peel essential oil has been widely used in traditional medicine. It contains many phytochemicals, such as terpenes, aldehydes, and ketones. Although many studies have verified the biological activities of fruit peels, the application of these natural materials are still limited.
The antibacterial property of three fermented fruit peel extracts were evaluated using two bacteria strains:
E. coli and
S. aureus. As shown in
Table 4, most of the fermented fruit peel extracts did not shown the antimicrobial activity, except pomegranate peels. In contrast, some research has shown the antibacterial capacity of banana peels with different extracts. Mokbel et al. [
12] reported the inhibition zone of ethyl acetate extract against
E. coli and
S. aureus to be 9 ± 0.2 and 12 ± 0.4 mm, respectively. In addition, different kinds of banana peel ethanol extract cultivated in Bali possess antibacterial activity against two bacteria strains, ranging from 11.00 to 14.77 and 9.00 to 13.37 mm, respectively [
13]. Another study on pomelo peel ethyl acetate extracts also indicated that the antibacterial effect on
E. coli and
S. aureus were 8.1 and 9.0 mm, respectively, at 75 ppm [
14]. Different extraction methods might lead to obtaining different secondary metabolite compounds. These phytochemical contents provide an antibacterial property in different bacteria cytotoxic mechanisms, such as cell membranes, cell wall biosynthesis enzymes, protein synthesis, or nucleic acid replication repair, which acts via an anti-metabolite mechanism ([
15]).
The importance of the antioxidant constituents from natural materials is raising interest among scientists; these antioxidants protect the body against reactive oxygen species (ROS). There was no correlation between enzyme concentration and antioxidant activity in PGP extract. It could be explained that antioxidant properties not only depend on antioxidants concentration, but also on the interaction and structure among antioxidants [
16]. Therefore, increasing enzyme concentration does not totally lead to an increase in the synergism among bioactive compounds in the mixture.
Many previous studies have shown the antioxidant potential of dried fruit peels when extracting with different kinds of solvent, such as methanol (IC
50 = 1.7 μg/mL in pomelo) and ethanol (IC
50 = 0.37 μg/mL in banana) [
17,
18]. According to Castro-Vazquez et al. [
19], several treatments, including far-infrared radiation, alkaline hydrolysis, enzyme treatment, and heat treatment, have been proposed to release more bioactive compounds from several species of citrus. Through this connection, it has been found that dried fruit peel extracts contain much higher concentrations of phenolic compounds than fresh ones, and hence exhibit greater antioxidant activity. Therefore, depending on the raw materials and methods, the results are different.
In the experiment, the antioxidant activity did not correlate with the enzyme concentration. Van Hung et al., [
20] reported the antioxidant activity of pomelo peel powder, using enzyme-assisted powder with water extraction over 60 min. It showed a lower DPPH scavenging ability compared with this study at any concentration (28.6% ± 1.1%). The studies of Ali et al. [
17] and Fidrianny et al. [
18] resulted in the IC
50 values of PP extract and BP extract being 1.7 μg/mL and 0.37 μg/mL, respectively, using dried peel with polar solvents. In ethanol extract, pomelo peels possess ability against oxidation, with an IC
50 value of 68.55 µg/mL [
21]. The free radical scavenging activity of fruit peel extracts vary among studies, depending on the origin of samples and extraction methods. According to Sun and Ho [
16], the antioxidant properties not only depend on antioxidants concentration, but also on the interaction and structure among the antioxidants. Therefore, increasing enzyme concentration does not totally lead to an increase in synergism among bioactive compounds in the mixture.
UVB light has proven to be a principal factor causing skin cancer. UVB rays (290–320 nm) have been found to be 1000 times more likely to cause sunburn than UVA rays, leading to skin cancer and affecting genes. Phytochemicals from plant, such as phenolics and flavonoids, are considered as a conjugated aromatic system with the capacity to absorb UV light [
22].
Punica granatum extract has widely applied as an oral supplement in skin care products, due to its potent photoprotection through the inhibition of free radicals or erythema and burning [
23]. In this study, pomegranate peel expressed anti-UV capacity, with the SPF value higher than a commercial sunscreen (Dermatone) at the enzyme concentration 1000 IU and 10% [
24] . In addition, pomegranate peel methanol extracts have also resulted in the highest SPF value among
B. monosperma flowers,
N. cadamba leaves,
P. granatum, and
C. citratus leaf extracts (6.06 at 40.0 μg/mL) [
25]. Banana peel ethanol extract with bisulfite immersion has demonstrated potential skin protection, with an SPF value 10.67, slightly higher than our findings [
26].